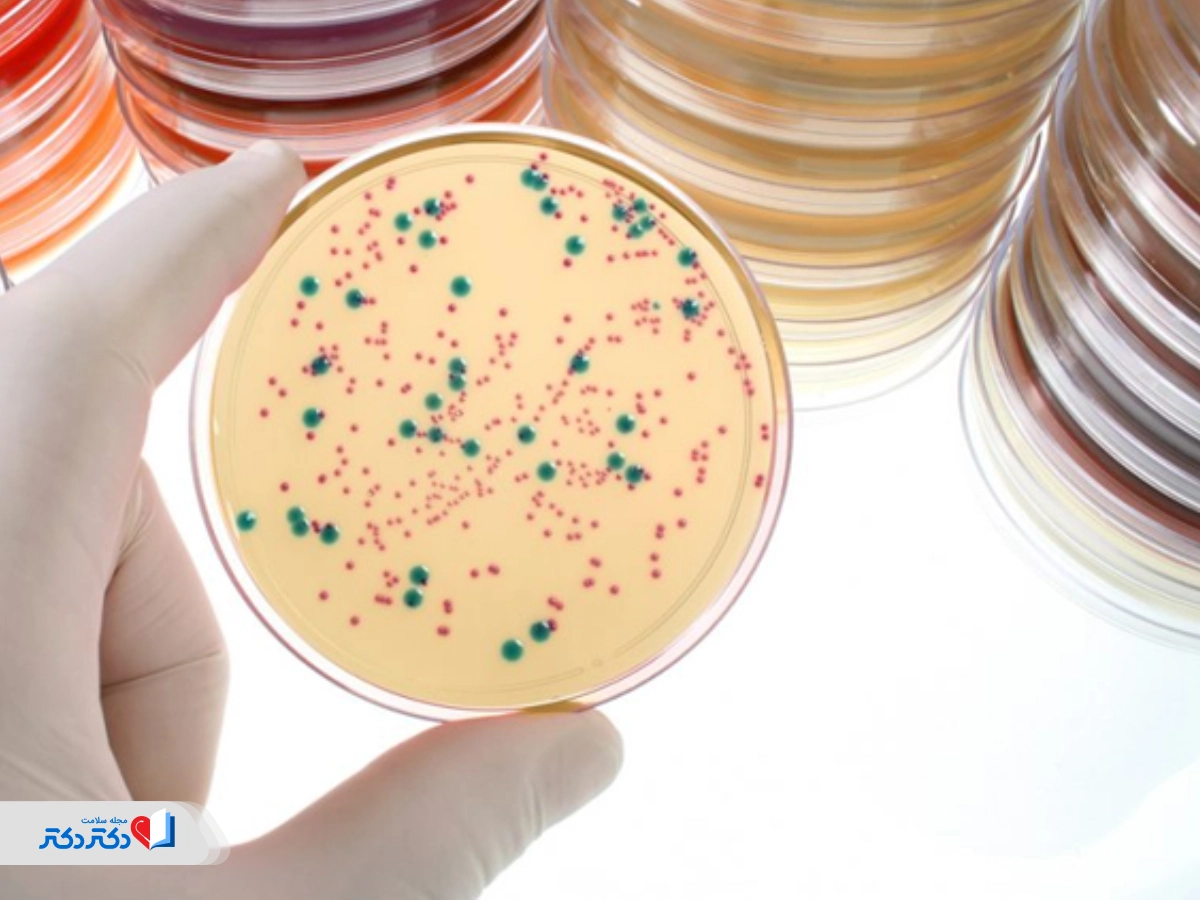
آزمایش الاستاز مدفوع

آزمایش مدفوع یکی از دقیقترین و درعینحال سادهترین روشها برای بررسی سلامت دستگاه گوارش است. این تست پرده از بیماریهایی برمیدارد که مدتها در بدن پنهان ماندهاند، همان بیماریهای گوارشی که در مراحل اولیه هیچ علامت ظاهری ندارند و رفتهرفته، با وخامت اوضاع، بروز پیدا میکنند. نتایج این آزمایش پزشک را از عملکرد معده، روده و وضعیت جذب مواد غذایی آگاه میکند و به تشخیص عفونت، انگل، التهاب و مشکلات گوارشی پیچیده میرساند. در این راهنما بخوانید آزمایش مدفوع برای چیست، چرا و چطور انجام میشود و تفسیر نتایجش به چه شکل است.
آزمایش مدفوع چیست و چرا انجام میشود؟
آزمایش مدفوع یک ابزار تشخیصی قاطعانه برای ارزیابی مشکلات سیستم گوارش و معده است. این تست حضور باکتریها، ویروسها و سایر میکروبهای موجود در مدفوع را مییابد و تشخیص زودهنگام بیماریهای دستگاه گوارش و سرطان روده بزرگ را ممکن میسازد. درصورت بروز علائم زیر، تست مدفوع برای شما تجویز خواهد شد:
- خون در مدفوع؛
- مخاط در مدفوع؛
- اسهال طولانیتر از ۳ روز؛
- درد یا گرفتگی معده؛
- حالتتهوع و استفراغ طولانیمدت؛
- تب.
پزشک تست مدفوع را برای تشخیص این بیماریها تجویز میکند:
- شقاق مقعد (بریدگی کوچک در مقعد)؛
- کمخونی (کمبود گلبولهای قرمز خون)؛
- کولیت (تورم یا سوزش در بخشی از روده بزرگ)؛
- پولیپ روده بزرگ (تودههای کوچک سلولی در روده بزرگ)؛
- سرطان روده بزرگ؛
- دیورتیکولوز (بیرونزدگی در روده).
- نارسایی لوزالمعده برونریز (EPC)؛
- خونریزی دستگاه گوارش (GI)؛
- هموروئید (وریدهای متورم در مقعد)؛
- عفونتها (باکتریایی، ویروسی یا انگلی)؛
- بیماری التهابی روده (IBD)؛
- استئاتوره (اسهال چرب)؛
- زخم معده.
مطالعه بیشتر: علت دفع مدفوع سخت

آزمایش مدفوع برای میکروب معده
آزمایش مدفوع برای میکروب معده بهشکلی کاملا غیرتهاجمی و بدون نیاز به آندوسکوپی، وجود هلیکوباکتر پیلوری را تشخیص میدهد و زنگ هشدار زخم معده، التهاب معده (گاستریت) و حتی سرطان معده را به صدا درمیآورد. نتیجه مثبت تست تأیید عفونت فعال در معده است و بهتر است قبلاز انجام تست، مصرف آنتیبیوتیکها، داروهای مهارکننده اسید معده یا بیسموت موقتا قطع شود.
آزمایش مدفوع برای کارت بهداشت
کاربرد دیگر آزمایش مدفوع برای کارت بهداشت و فعالیت مجاز در مشاغل مرتبط با مواد غذایی و خدمات عمومی مثل رستورانها، نانواییها، آرایشگاهها و … است. جواب منفی این آزمایش تأیید میکند که فرد ناقل بیماریهای عفونی، انگل و میکروبهای بیماریزا نیست و نقش پررنگی در حفظ سلامت عمومی جامعه دارد.
آزمایش مدفوع نوزاد و کودک
آزمایش مدفوع سلامت دستگاه گوارش نوزاد و کودک را ارزیابی میکند و مشکلات گوارشی، عفونی و جذب را رصد میکند. پزشک کودک بهمحض مشاهده مجموعه علائم اسهال، یبوست شدید، نفخ، استفراغ، کاهش وزن، بیاشتهایی یا وجود خون در مدفوع، برای بررسی وجود عفونتهای انگلی و باکتریهای بیماریزا نسخۀ این آزمایش را مینویسد. 
انواع آزمایش مدفوع
در ادامه میگوییم آزمایش OB، کشت، کالپروتکتین، الاستاز و آزمایش مدفوع سه نوبته برای چیست.
آزمایش مدفوع سه نوبته و سه مرحلهای
هدف آزمایش مدفوع سه مرحله ای تشخیص دقیقتر انگلها و تخمریزی آنها در دستگاه گوارش است. در این تست، نمونه مدفوع فرد در سه نوبت مختلف (معمولا طی سه روز متوالی) جمعآوری و بررسی میشود تا دقت تشخیص بیشتر شود.
آزمایش OB مدفوع
آزمایش ob مدفوع بهمنظور مشاهده و تشخیص خون مخفی در مدفوع کاربرد دارد، خونی که با چشم دیده نمیشود. نتیجه این آزمایش تشخیص زخم معده، پولیپ روده، بواسیر، التهاب روده یا حتی سرطان دستگاه گوارش را برای پزشک آسان میکند.
آزمایش کشت مدفوع
در آزمایش کشت مدفوع، نمونه مدفوع آزمایشدهنده در یک محیط مخصوص آزمایشگاهی کشت میشود تا پزشک پی به حضور باکتریها، ویروسها و قارچهای بیماریزا ببرد. این تست برای تشخیص عفونتهای رودهای ناشی از باکتریهایی مثل سالمونلا، شیگلا یا ایکولای فوقالعاده پرکاربرد است.
آزمایش کالپروتکتین مدفوع
پروتئین کالپروتکتین درصورت التهاب دیواره روده افزایش مییابد و این آزمایش مقدار این پروتئین در مدفوع را اندازه میگیرد. پزشک از این تست برای تشخیص و پیگیری بیماریهای التهابی روده مانند کولیت اولسراتیو و کرون کمک میگیرد و با مرور نتایج آن، التهاب واقعی را از مشکلات عملکردی مثل سندرم روده تحریکپذیر متمایز میکند.
آزمایش الاستاز مدفوع
این آزمایش مدفوع مقدار آنزیم الاستاز که لوزالمعده ترشح کرده و وارد مدفوع شده را اندازه میگیرد. کاهش این آنزیم بیانگر ضعف پانکراس است. بنابراین برای تشخیص نارسایی پانکراس، فیبروز کیستیک یا پانکراتیت مزمن میتوان از نتایج آن استفاده کرد.
مطالعه بیشتر: بی اختیاری مدفوع
نحوه انجام آزمایش مدفوع
تست مدفوع ازجمله تستهای پیچیده با آمادگی ویژه نیست. کافیست دستورالعملهای پزشک در مورد قطع موقت یکسری داروها یا پرهیز از یکسری غذاها (فقط بهمدت چند روز) را جدی بگیرید و موبهمو رعایت کنید. احتمالا پزشک مصرف گوشت قرمز، مکملهای ویتامین C یا غذاهای سرشار از آهن را محدود کند. همچنین اگر آنتیبیوتیک، آنتیاسید یا ملین مصرف میکنید، پزشک را در جریان قرار دهید.
شرایط نمونهگیری و ناشتا بودن
آزمایش مدفوع نیازی به ناشتایی ندارد و نکات دیگری در مورد این آزمایش اهمیت دارند، مثلا اینکه:
- نمونه باید تازه باشد و بلافاصله پس از جمعآوری (حداکثر ظرف یک ساعت) به آزمایشگاه تحویل داده شود؛
- نمونه مدفوع نباید با آب، ادرار یا مواد شوینده برخورد کند، چون احتمال تغییر نتایج وجود دارد؛
- بهتر است از ظرف مخصوص نمونهگیری در آزمایشگاه برای نگهداری نمونه استفاده شود؛
- در تستهای کشت مدفوع یا کالپروتکتین، نمونه باید در دمای یخچال نگهداری شود تا فاسد نشود.
نحوه گرفتن نمونه برای نوزاد
نحوه گرفتن آزمایش مدفوع نوزاد به دقت و مراقبت بیشتری نیاز دارد. اگر نمونه را از پوشک نوزاد جمع میکنید، دقت کنید پارچه پوشک کاملا تمیز و فاقد پودر جاذب باشد. از یک کاردک نمونهگیری تمیز برای جداسازی نمونه استفاده کنید و آن را در ظرف استریل نمونهگیری آزمایشگاه بریزید. نمونه مدفوع نوزاد نباید با ادرار، آب یا کرمهای پوستی تماس پیدا کند. بعداز آنکه عملیات نمونهگیری با موفقیت به پایان رسید، آن را ظرف کمتر از ۱ ساعت به آزمایشگاه برسانید.

تفسیر نتایج آزمایش مدفوع
برگه آزمایشی که تحویل میگیرید، وضعیت مدفوع را با یکی از این دو واژه معلوم میکند: منفی (Negative) یا مثبت (Positive). منفی بهمعنی سلامت مدفوع، مثبت بهمعنی وجود ناهنجاری یا عامل بیماریزا. همچنین ممکن است عبارات Not detected یا Not seen جایگزین Negative و عبارات detected یا seen جایگزین Positive شوند.
اگر سررشتهای در خودتفسیری تستهای آزمایشگاهی ندارید، با خدمات آزمایش در محل دکتردکتر، هم خیالتان را بابت نمونهگیری در محل دلخواهتان راحت کنید، هم تفسیر تست را از زبان پزشکان متخصص بشنوید.
معنی Yeast در آزمایش مدفوع
Yeast در آزمایش مدفوَ بیانگر وجود قارچ (معمولا قارچ کاندیدا) در مدفوع است. مقادیر اندک این قارچ طبیعیست اما تعداد زیاد آن نشانۀ رشد بیشازحد قارچها در روده (معمولا بهدلیل مصرف طولانیمدت آنتیبیوتیکها، ضعف سیستم ایمنی یا تغذیه نامناسب) است.
معنی RBC و WBC در آزمایش مدفوع نوزاد
RBC نام اختصاری گلبول قرمز و وجود rbc در آزمایش مدفوع نوزاد بهمعنای خونریزی دستگاه گوارش است. این خونریزی معمولا ناشی از آلرژی به پروتئین شیر، التهاب روده، شقاق مقعد یا عفونت است.
WBC نیز نام اختصاری گلبول سفید و وجود wbc در آزمایش مدفوع نوزاد بیانگر التهاب یا عفونت در روده است. این فاکتور فقط در موارد ابتلا به اسهال عفونی یا کولیت در آزمایش مدفوع نوزاد دیده میشود.
مقادیر بسیار کم RBC یا WBC در نوزادان گذرا بوده و جای نگرانی ندارد؛ اما مقادیر بیشازحد آنها نیازمند بررسی و درمان تخصصی است.
خواندن جواب آزمایش مدفوع
برگه نتایج آزمایش مدفوع چند بخش مهم دارد:
- فرم (Form): بیانگر شکل طبیعی و قالبدار مدفوع است.
- قوام (Consistency): بافت مدفوع را توصیف میکند. حالت نیمهفرمدار طبیعی است؛ شل یا آبکی بودن نشاندهنده اسهال یا عفونت است؛
- موکوس (Mucus): وجود موکوس زیاد نشانه التهاب یا تحریک روده است؛
- WBC (گلبول سفید): مقادیر زیاد آن بیانگر عفونت یا التهاب رودهای است؛
- RBC (گلبول قرمز): وجود آن بیانگر خون در مدفوع است؛
- Parasite / Ova: گویای وجود انگل یا تخم آن و نشانۀ عفونت انگلی است؛
- Fat droplets: وجود چربی زیاد نشاندهنده سوءجذب در روده، اختلال عملکرد لوزالمعده، بیماری سلیاک، فیبروز کیستیک و مشکلات اینچنینی است.
نتایج آزمایش مدفوع زمانی طبیعی است که:
- مقدار مخاط در مدفوع کم باشد؛
- رنگ مدفوع بزرگسالان قهوهای باشد؛
- رنگ مدفوع سبز نوزادان سبز باشد؛
- دفع چربی کمتر از ۶ گرم در روز باشد.
نتایج آزمایش مدفوع زمانی غیر طبیعی است که:
- رنگ مدفوع بزرگسالان سیاه، قرمز، سفید، زرد، سبز یا به رنگ خاک رس باشد؛
- مدفوع کاملا آبکی یا حسابی سفت باشد؛
- خون، مخاط و چرک فراوان در مدفوع باشد؛
- الیاف گوشت هضمنشده در مدفوع دیده شود؛
- باکتریهای مضر، ویروسها، قارچها یا انگلها یافت شوند؛
- مقادیر آنزیمهایی مثل تریپسین یا الاستاز کم باشد.
مطالعه بیشتر: مدفوع چرب نشانه چیست؟

هزینه آزمایش مدفوع
هزینه آزمایش مدفوع در ایران به نوع آزمایش، آزمایشگاه انتخابی و موقعیت جغرافیاییتان بستگی دارد. همچنین مهم است تست را بهصورت جداگانه یا بهعنوان جزئی از یک پکیج چکاپ کامل انجام میدهید. طبق جدول تعرفه خدمات آزمایشگاهی رسمی، هزینه تست کشت مدفوع در آزمایشگاههای تهران حدودا ۱۲۰ هزار تومان است و بهای پرداختی برای اندازهگیری آنتیژنهای دیگر کمتر از این مقدار است.
نکات مهم قبل و بعد از آزمایش مدفوع
رعایت بهداشت، دقت در جمعآوری نمونه و تحویل بهموقع آن قبل و بعداز آزمایش مدفوع، نتایج دقیق و قابلاعتماد را تضمین میکند. در ادامه دقیقتر به شرایط نمونهگیری و عوامل تأثیرگذار بر نتایج این تست اشاره میکنیم.
شرایط نمونهگیری صحیح
اگرچه آزمایش مدفوع پیشآمادگی خاصی ندارد، برای دقیقترین نتایج باید شرایط نمونهگیری را بهدرستی پیاده کنید. مثلا اینکه:
- از ظرف استریل مخصوص آزمایشگاه برای نگهداری نمونه استفاده کنید؛
- نمونه را حداکثر تا ۱ ساعت پس از جمعآوری به آزمایشگاه دهید. درغیراینصورت، در یخچال (دمای ۲ تا ۸ درجه) نگه دارید؛
- قبلاز جمعآوری مدفوع مثانه را تخلیه کنید تا نمونه مدفوع با ادرار مخلوط نشود؛
- نگذارید مدفوع نمونه با آب یا مواد شوینده تماس پیدا کند؛
- حدودا یک قاشق چایخوری برای این آزمایش کافیست، مگر پزشک مقدار بیشتری درخواست کند؛
- درصورت توصیه پزشک، نمونهگیری را چند نوبت تکرار کنید؛
- حتما دستکش بپوشید تا از انتشار عفونت جلوگیری شود؛
- نمونهگیری را تا پایان قاعدگی به تعویق بیندازید؛
- هرگز نمونه مدفوع را از روی کاسه توالت برندارید.
داروها و خوراکیهای تاثیرگذار روی نتایج
نتیجه آزمایش مدفوع شما مستقیما تحتتأثیر این موارد است:
- تغییرات اخیر در رژیم غذایی بر ترکیب مدفوع اثر میگذارد؛
- مصرف آنتیبیوتیکها، ملینها یا آنتیاسیدها یافتههای آزمایش مدفوع را تغییر میدهد؛
- نمونههای آلوده که در مکان و وضعیت نامناسب نگهداری شدهاند، نتایج درست و دقیق ارائه نمیدهند؛
- بیماریهای مزمن مثل IBD یا دیابت بر خواص مدفوع اثر میگذارند و نتیجه تست را بههم میریزند.
کلام آخر دکتردکتر
آزمایش مدفوع نه یک برگه پر از اعداد و اصطلاحات پزشکی، که آینۀ سلامت دستگاه گوارش است. اهمیت واقعی این تست زمانی برای ما واقعا قابللمس میشود که بدانیم بسیاری از بیماریهای گوارشی با تشخیص در مراحل اولیه درمانپذیر و قابلکنترل هستند. بنابراین آزمایش مدفوع بهصورت دورهای نهفقط یک اقدام آگاهانه، که بخشی ضروری از مراقبتهای پیشگیرانه است، بهخصوص برای کسانی که سابقۀ بیماریهای گوارشی دارند.
در سامانه پزشکی دکتردکتر، درخواست آزمایش در محل را اینترنتی ثبت کنید، تکنسینهای خبره را به خانه بیاورید و از حالا به بعد دیگر برای تشخیص زودهنگام بیماریها به زحمت نیفتید.
سوالات متداول
منابع
healthdirect clevelandclinic apollohospitals kidshealth
